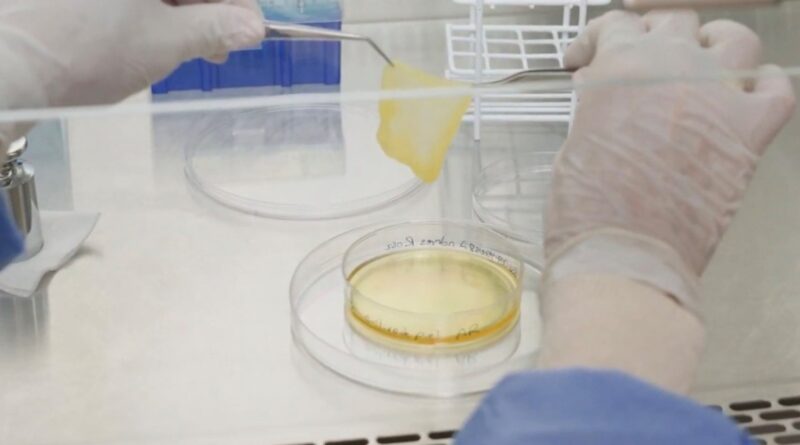

Un centro de salud argentino dio un paso significativo en el campo de la bioingeniería de tejidos al desarrollar de manera exitosa piel nueva cultivada en laboratorio para el tratamiento de heridas complejas.
La técnica, conocida científicamente como cultivo autólogo dermo-epidérmico para autoinjerto, consiste en la extracción de una pequeña muestra de piel del propio paciente, que luego se cultiva en laboratorio para generar nueva piel. Ese tejido se utiliza posteriormente para cubrir o reparar zonas afectadas, favoreciendo una regeneración más segura y eficaz.
Este avance médico fue desarrollado con el objetivo de mejorar la recuperación de lesiones cutáneas, como quemaduras graves, úlceras crónicas y otras patologías en personas con dificultades para regenerar tejidos. Hasta el momento, los tratamientos disponibles se basaban en piel donada de otra persona (aloinjerto), piel de origen animal (xenoinjerto) o materiales sintéticos, alternativas que presentan mayores riesgos y limitaciones.
Bioingeniería
Según un informe del Hospital Italiano, el doctor Luis Mazzuoccolo, jefe del Servicio de Dermatología y del Equipo de Bioingeniería de Tejidos, explicó que en las quemaduras de tercer grado se pierden las tres capas de la piel, lo que vuelve indispensable un reemplazo rápido de la dermis, ya que su ausencia implica la pérdida de funciones esenciales como la elasticidad y la sensibilidad, con consecuencias potencialmente graves para el paciente.
Extracción: se obtiene una porción mínima de piel del paciente, compuesta por dermis y epidermis, generalmente de la zona inguinal, elegida por su alta capacidad de cicatrización.
Cultivo: la muestra se cultiva en plasma rico en plaquetas, que aporta factores de crecimiento y permite la adhesión celular. Al utilizar componentes del propio paciente, se reduce al mínimo el riesgo de rechazo, infecciones o reacciones inmunológicas.
Autoinjerto: entre los 10 y 17 días, la lámina de piel cultivada se coloca sobre la superficie de la herida, protegida con gasa húmeda y un vendaje compresivo.
Cierre de la lesión: entre 30 y 120 días después del autoinjerto, se logra la regeneración completa del tejido, considerándose la lesión curada cuando se restituye la última capa de la piel.
Resultados acelerados y mayor seguridad
El objetivo central de esta tecnología innovadora es reactivar el proceso natural de cicatrización y lograr una regeneración funcional y estética superior.
Los resultados iniciales son alentadores: en un paciente con quemaduras, la piel tratada con este método recuperó el 95% de su elasticidad, frente al 75% alcanzado con piel artificial, marcando una mejora sustancial en la calidad del tejido regenerado.
Además, el procedimiento presenta ventajas clave para los pacientes:
Menor riesgo: al utilizar exclusivamente piel autóloga, se elimina el rechazo inmunológico y el riesgo de contaminación biológica.
Mejora estética: ofrece una cicatrización más natural, estable y homogénea que los injertos sintéticos.
Procedimiento mínimamente invasivo: la obtención de la muestra es ambulatoria, con anestesia local, y en pacientes quemados se realiza durante la internación.
Menor costo: el desarrollo de piel autóloga cultivada permite una reducción significativa de costos frente a los sustitutos dérmicos comerciales.
Este desarrollo posiciona a la medicina argentina en un lugar destacado dentro de la innovación en tratamientos regenerativos, con impacto directo en la calidad de vida de los pacientes y en la sustentabilidad del sistema de salud.